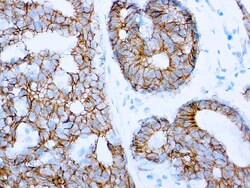
Diagnostic Biosystems&nbsp;E-CADHERIN E-Cadherin (SPM471)

Incubators
Incubators are designed to provide precise climate control, temperature uniformity, and contamination prevention for a variety of research and clinical applications. Different chamber types, materials, sizes, and options are available, including: direct-heat or water-jacketed CO2 incubators, dry block incubators, environmental chambers, hatching incubators, hybridization incubators, plant growth incubators, and refrigerated incubators.
Standard incubators are commonly used for microbiological cultures and tests. Many have features that include decontamination programs, locking mechanisms, alarms, digital displays, and transparent doors for visibility. Standard incubators may use gravity convection, mechanical convection, or dual convection for heat control and uniformity.
Specialized incubators may also be found for a range of test procedures, including direct-heat or water-jacketed CO2 incubators, refrigerated incubators and environmental chambers; and dry block, hatching, hybridization, and plant growth incubators.
Carbon dioxide (CO2) incubators are used to create a specific environment and are used primarily for microbiological and cell cultures. Available in water-jacketed or direct-heat options, other features include in-chamber HEPA air filtration, touchscreens, stackability, 100% pure copper surfaces, and sterilization cycles.
Refrigerated incubators offer a range of temperatures that may be above or below the ambient temperature. Designed to keep samples at a specific fixed temperature, this equipment can be found in pharma, food, cosmetics, and water testing labs. Available features include Wi-Fi connections, programmability, and color touch screens.
Environmental chambers let you control the light, humidity, air pressure, and atmosphere and are typically used for drug stability studies, shelf-life testing, controlled temperature storage, and insect or other biological research applications.